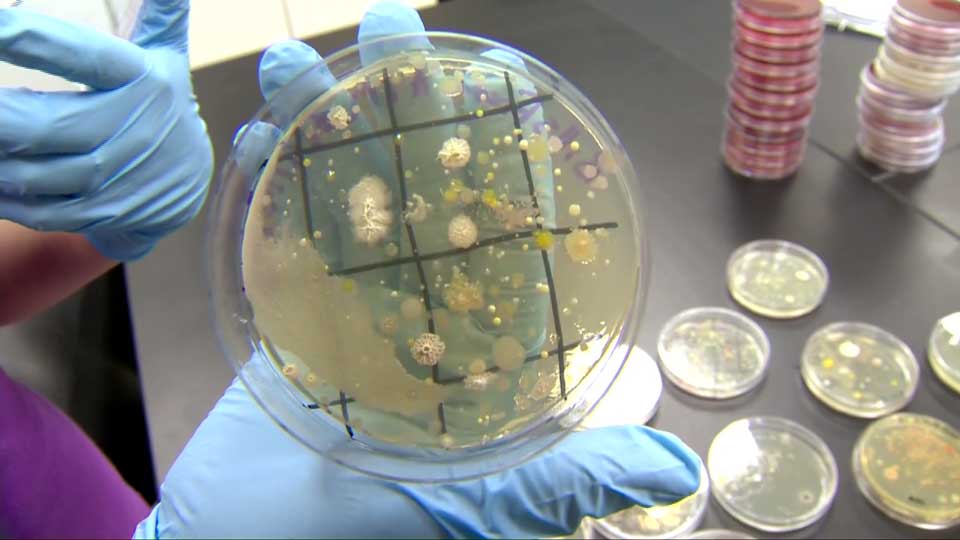
Lab tests show your money can be incredibly dirty
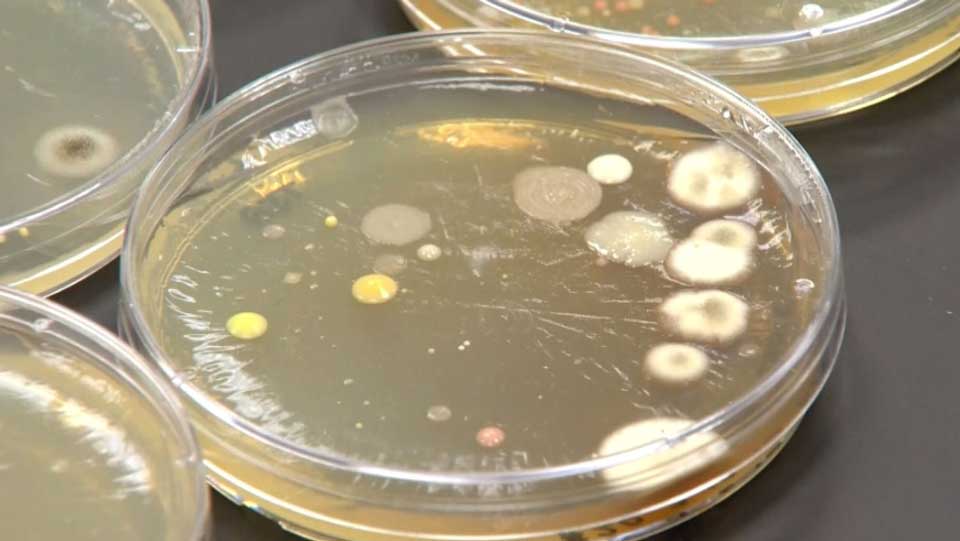

WATCH ABOVE: Tests show cash is often covered in harmful bacteria and viruses. KUSA’s Mark Koebrich reports.

TORONTO – The cash in your wallet may be useful for buying things but did you know there’s a chance it could also make you terribly sick?
Researchers at Metropolitan State University of Denver were recently given samples of coins and bills from various locations around Colorado’s capital and their results are simply alarming.
“It says you’ve got feces, you’ve got fecal contamination, and that could transmit all kinds of disease,” Dr. Rebecca Ferrell described one sample to KUSA.
READ MORE: What docs found when they studied eye surfaces of contact lens users
The money was collected from banks, grocery stores, fast food and typical sit-down restaurants. One culture taken from an ATM at a bank and shown to a KUSA news crew was covered in filth and bacteria.
Dr. Ferrell said her team found the ‘usual suspects’ – salmonella, shigella, typhoid and clostridium – better known as C. difficile.
“Most bacteria are harmless. Many of them are actually helpful,” she explained. “We carry lots of bacteria on our bodies that are helping us with things.”
So what can you do to avoid infection each time you reach into your pocket or wallet? Stay clean, for starters.
Health Canada recommends washing your hands frequently and lists a number of benefits on their website.
“Not only will it help keep you healthy, it will help prevent the spread of infectious diseases to others.”

Comments